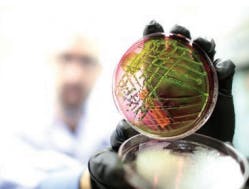
0723a5 0723a5

LASER-INDUCED FLUORESCENCEBioVigilant's new IMD-W instantaneous microbial detection system for real-time pharmaceutical water monitoring targets applications where it may be used immediately to manage and mitigate risks, increase process understanding and save energy through better use of heat sanitization cycles. Using laser-induced fluorescence, the IMD-W system simultaneously measures particle size and determines whether a particle is biologic or inert. This optical design does not require staining or reagents, and incorporates three light scatter signals with advanced software algorithms to detect biologic particles and discriminate non-biologic "interferent" materials. The system may be used on-line for continuous monitoring, or at-line, for point-of-use samples and in lab settings. BIOVIGILANT520-292-2342
MAINTAINS ACCURATE FLOW RATEThe new MAS-100 VF active air sampler was developed for controlled environments requiring microbial control. Regulatory expectations require air monitoring in manufacturing facilities because microbial contamination may influence quality and reduce shelf life. The MAS-100 VF uses 90 - 100 mm standard petri dishes, is easy to handle and easy to operate. Its compact design is ideal for monitoring your environment. The unit's electronic speed control maintains an accurate flow rate.EMD MILLIPORE800-645-5476
DETECTS, IDENTIFIES ADVENTITIOUS VIRUSESGreiner Bio-One has developed a new test system for the detection and identification of adventitious viruses in biopharmaceutical products. The ViroInspect test kit detects viruses that are relevant in the context of current safety regulations and/or have caused contamination in the past. The system also identifies stable viruses without a membrane envelope that are difficult to remove and are used as model viruses in viral clearance studies. In addition to short throughput times and high sensitivity, ViroInspect benefits from impressive specificity, robustness and repeatability. It analyses data quickly and presents clear, precise results for a rapid decision-making process.GREINER BIO-ONE NORTH AMERICA704-261-7865
ENHENCED RANGE of DETECTIONPall ForteBio LLC, a division of Pall Corp., has introduced a Dip and Read Anti-CHO (Chinese hamster ovary) Host Cell Protein (HCP) detection kit for quantitation of residual HCPs. Kit users benefit from faster time to results, enhanced range of detection and better assay precision, all of which accelerate the drug development timeline while improving safety and efficacy. The kit can also be applied in production phases to confirm reduction or removal of HCP. The high-precision assays have 5-10 percent CVs, and the design allows the analysis to be done, without supervision, in 65 to 90 minutes, according to the company.PALL CORPORATION516-801-9944
MICROBIAL TESTING SERVICESCharles River is a global provider of comprehensive cGMP-compliant microbial testing services. Specializing in bacterial and fungal identification and strain typing of environmental isolates, its Accugenix sequence-based and MALDI-TOF technologies provide accurate and reliable solutions to more than 1,000 facilities. The company says its laboratories have tested and identified more microorganisms than any other company or service laboratory, which has allowed them to develop and validate proprietary libraries and methods of interpretation.CHARLES RIVERwww.criver.com/accugenix 302-292-8888
NON-DESTRUCTIVE TESTINGThe Growth Direct System is an automated, non-destructive, rapid detection and enumeration technology for microbial quality control testing in manufacturing. The system delivers non-destructive testing in the areas of bioburden testing, environmental monitoring and sterility testing. The technology detects contamination earlier, eliminates error-prone manual steps, and aligns closely to current regulatory practices.RAPID MICRO BIOSYSTEMS978-349-3604
RESULTS IN HOURS, NOT WEEKSThe Roche MycoTOOL PCR-based Mycoplasma Detection Kit, an FDA-accepted release test method for select biopharmaceutical products, provides accurate and reliable results in hours instead of weeks, the company says. In contrast to culture testing that requires 28 or more days, the MycoTOOL kit tests cellular samples and noncellular samples in less than six hours, offering biopharmaceutical companies fast turnaround time, faster product release, and accelerated response rates.ROCHE317-521-3112
VALIDATED REFERENCE LIBRARIESDesigned for a QC microbiology lab, the Life Technologies' MicroSEQ Rapid Microbial Identification System features the 3500 Genetic Analyzer. The system delivers high accuracy and time to results for bacterial and fungal identifications in an easy-to-use platform. It achieves high throughput and accurate results in less than five hours. It can be fully validated and implemented in approximately four months. It also enables 21 CFR Part 11 compliance.LIFE TECHNOLOGIES800-955-6288
About the Author
Katie Weiler
Managing Editor
Sign up for our eNewsletters
Get the latest news and updates